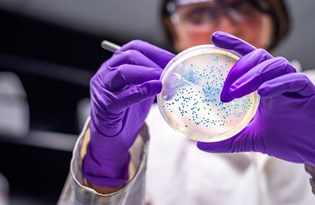
'Corona virüs bir yılda 12 bin mutasyon geçirdi'

İlişkili Haberler

Pfizer/BioNTech aşısının, corona virüsün Brezilya mutasyonuna karşı etkili olduğu açıklandı
'Corona virüs bir yılda 12 bin mutasyon geçirdi'

Beşşar Esad ve eşi corona virüs oldu
Bununla birlikte Goldsmith ve eşi, Abu Dabi'nin iktidardaki hanesinin bir üyesinin daveti üzerine BioNTech / Pfizer aşısını yaptırdı. Goldsmith yaptığı açıklamada, “Niyetimiz kesinlikle burada aşı olmak değildi. Ancak, fırsat kendini gösterdiğinde minnetle yaptırdık. BAE, isteyen herkese aşı yapıyor. Biz sadece uygun zamanda uygun yerde olduğumuzu gördük” ifadelerini kullandı.DÜNYANIN EN HIZLI AŞILAMA PROGRAMLARINDAN BİRİ SAHİP
Diğer taraftan, 10 milyonluk bir nüfusa sahip BAE, 6 milyondan fazla vatandaşına aşı uygulayarak dünyanın en hızlı aşılama programlarından birine yön verdi. Ayrıca Çin’in Sinopharm aşısı için 3. aşama klinik denemeleri yürüten ve bu aşıyı imal etmeyi planlayan BAE, tüm sakinlerini aşılamak için yeterli tedariğe sahip.

Bu kapsamda, küçük bir SoftBank yöneticisi grubunun yolculuk hakkında doğrudan bilgi veren iki kişi aracılığıyla Ocak ayında Londra'dan BAE'ye gittiği ifade edildi. Grup üyeleri, bankanın “Hayal Gücü ve Öngörü Fonu’nu yöneten Rajeev Misra ile birlikte aşı oldu. Ancak, SoftBank konuyla ilgili yorum yapmayı reddetti.
Bununla birlikte, SoftBank’ın “Hayal Gücü ve Öngörü Fonu”, Abu Dabi’nin finansal merkezinde bir yere sahipken, aynı zamanda Suudi Arabistan’ın e Kamu Finansmanı Fonu’na, ciddi yatırım yapan yapan kurumlar arasında yer alıyor.

Abu Dabi'de yerleşik olmayan bu kişilerin aşılanmasına yardım eden ve ismini vermek istemeyen bir yetkili, "Onları aşılatmak çok daha güvenli. Bunu başarmak kolay, sadece birkaç gün sürüyor” ifadelerini kullandı."EMİRLERİN KENDİ AŞI ZULALARI VAR"
Öte yandan, zengin aşı tatilcilerinin BAE’ye kimsenin dikkatini çekmemek için özel jetleriyle geldiği ve lüks otellerde kaldığı belirtildi. Lüks otellerden birinin yöneticisi, "Bağlantıları olan insanlar buraya geldiler ve aşıları oldular. Emirlerin kendi aşı zulalarına erişimleri var” dedi.
Bununla birlikte BAE’nin zengin abancılara aşı sağlaması bazı ülkelerde tepkiye neden oldu.
Daha önce Kanada’nın en büyük emeklilik fonunun başkanı olan Mark Machin, aşı olmak için Kanada’nın tecrit tavsiyesine aykırı olarak BAE’ye gittiğinin ortaya çıkmasının ardından istifaya çağrıldı. İspanya Kralı Felipe'nin iki kız kardeşi, yerel medyanın Abu Dabi'de aşıyı yaptırdıklarını bildirmesinin ardından, uluslarının tepkisine de maruz kaldı.OTELDE CORONA VİRÜS PARTİSİ (ARŞİV)








